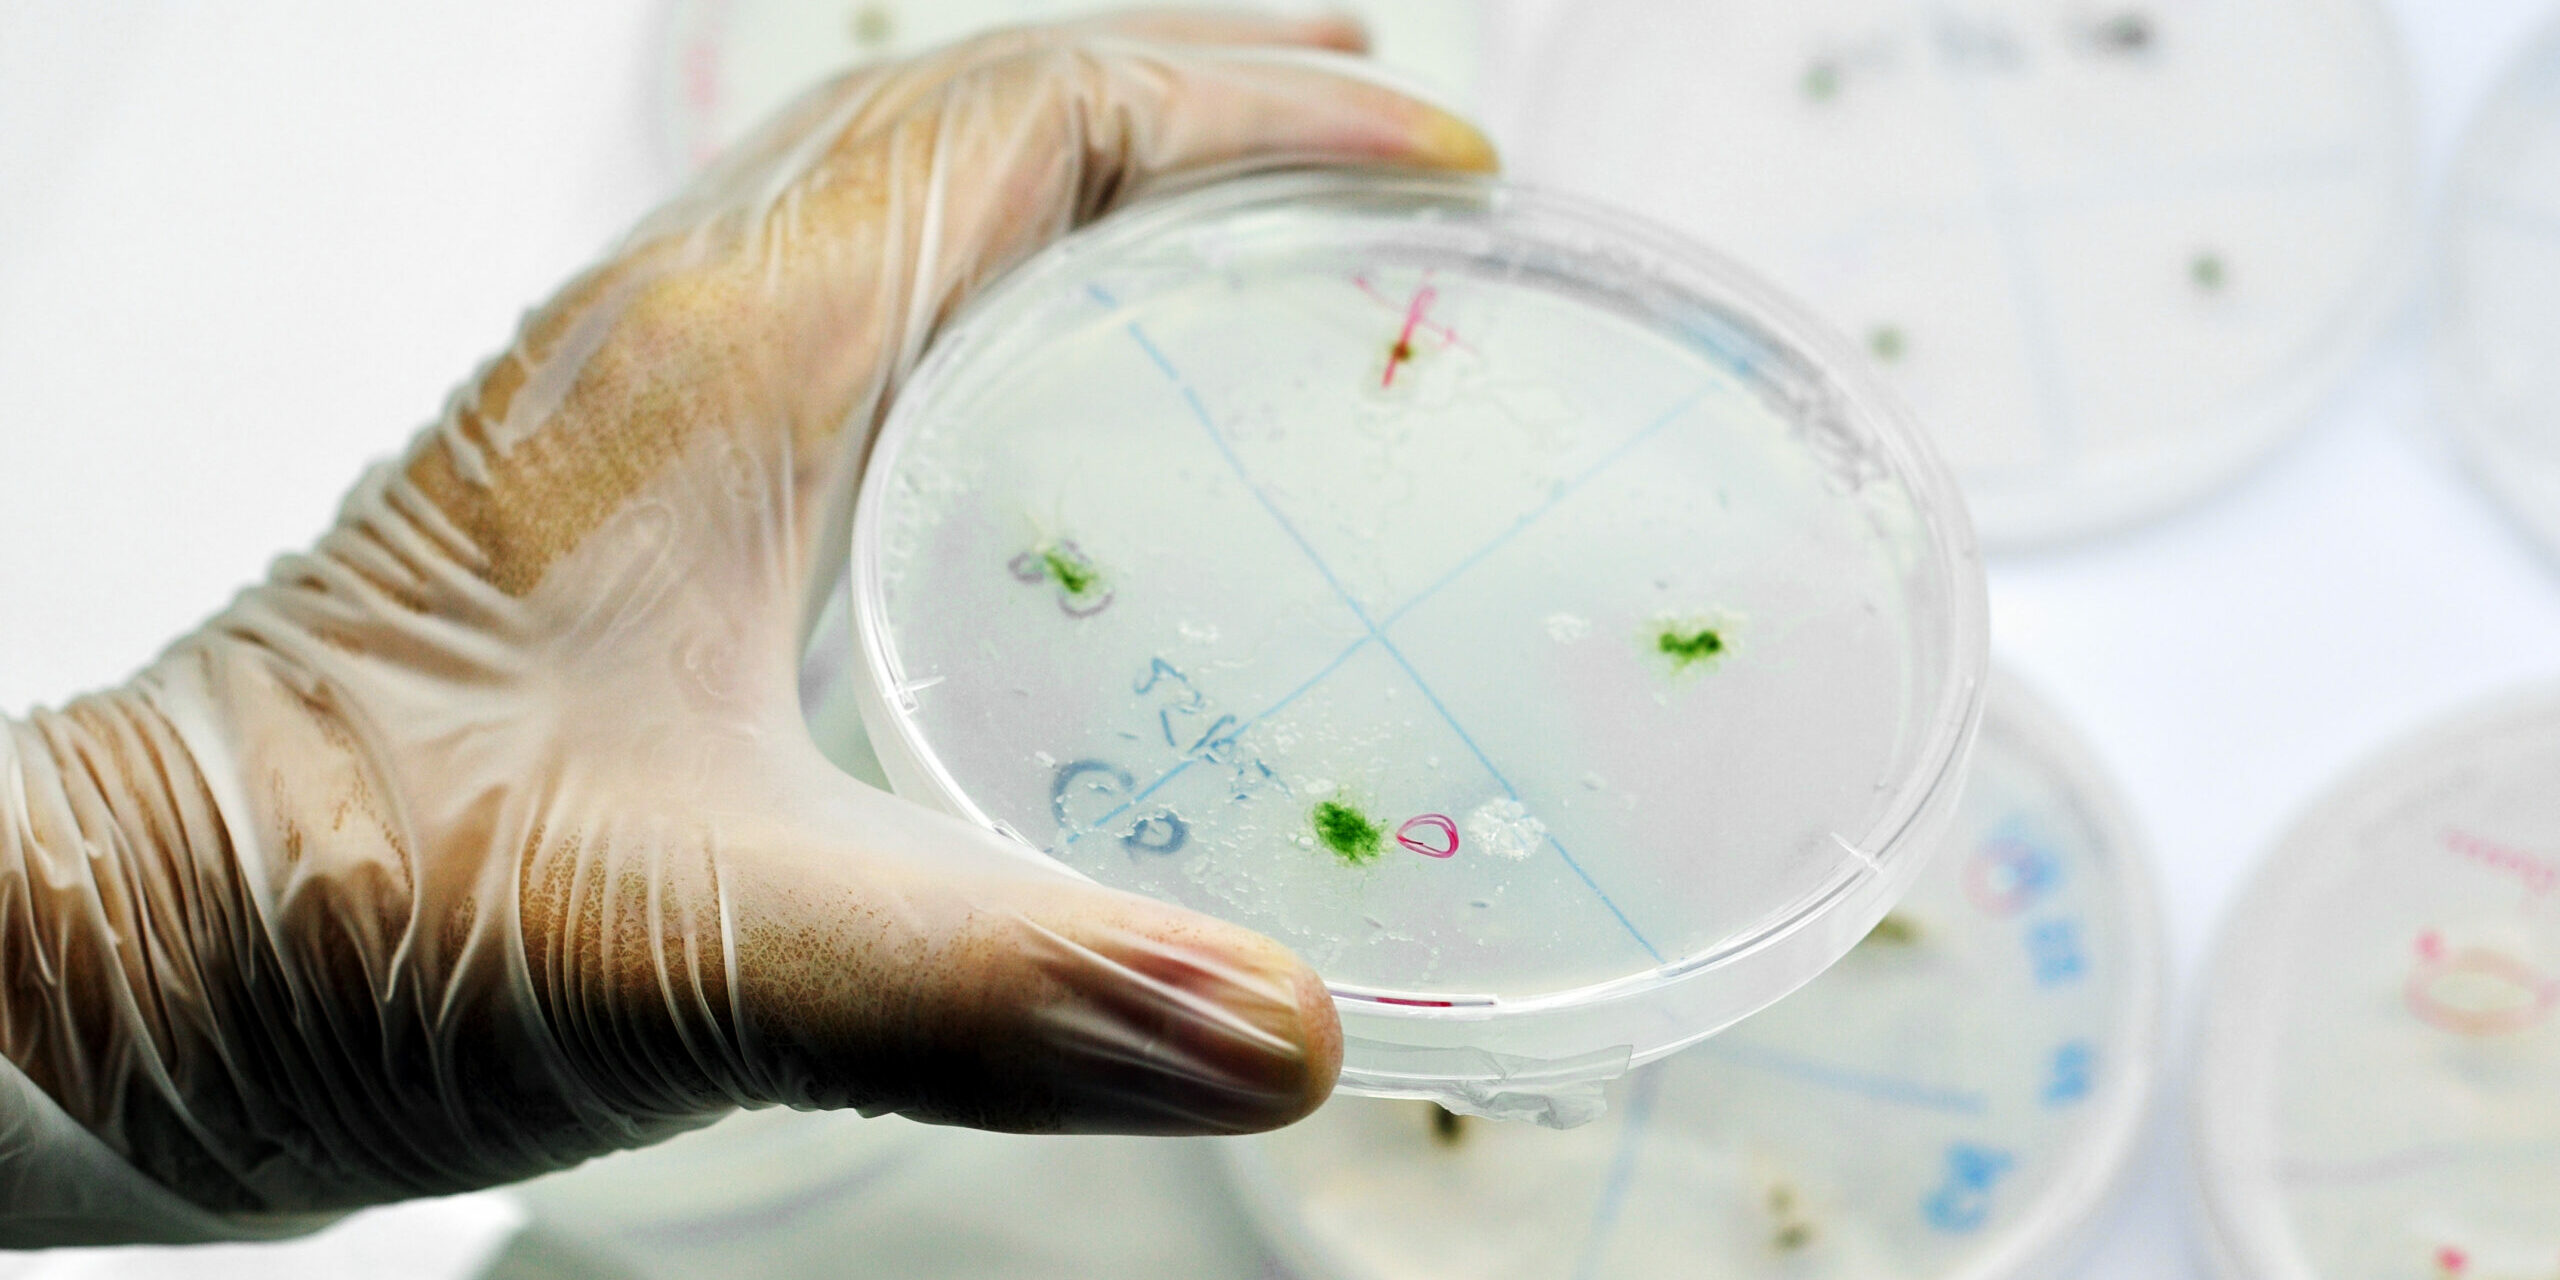

CRT
Siège social
97490 Sainte Clotilde
Région
La Réunion
Mots-clés
Le Citeb est un centre technique, de recherche et de valorisation des milieux aquatiques dont les activités ont pour perspectives d’accompagner le développement de l’économie bleue à la Réunion, tout en veillant à mieux connaître ces milieux aquatiques afin de mieux les préserver. Nos domaines d’activités s’organisent autour de l’aquaculture, des biotechnologie, de la pêche et de l’environnement marin.
Conseil, expertise, appui technique, transfert de technologie, formations, montage et mise en œuvre opérationnelle de projets de recherche, prestations sur mesure, analyses en laboratoire et centre de ressources technologiques sont les missions de l’équipe technique pluridisciplinaire du Citeb au service des acteurs.
- Prélèvement en mer © CITEB – crédit photo
- Pèche calamar © CITEB – crédit photo
- Culture microalgue © CITEB – crédit photo
- Laboratoire © CITEB – crédit photo
- Flacon culture © CITEB – crédit photo
- Salle de chimie © CITEB – crédit photo
- Boite de petri © CITEB – crédit photo
- Biofouling © CITEB – crédit photo
- Aquaculture © CITEB – crédit photo